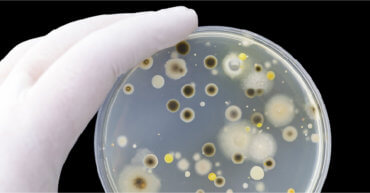
https://www.apollohealthco.com/wp-content/uploads/2020/08/Artboard-1-370x193.jpg

September 18, 2020
A Day in The Life

By Julie Gregory, Chief Health Liaison for Apollo Health
I’m regularly asked to share what a typical day on the Bredesen protocol looks like for me. I always hesitate for a couple of reasons. First, I worry that people will find my version of the protocol too extreme and think that they have to mimic what I do. Nothing could be further from the truth! Keep in mind that I’ve been using this approach for eight years before it was a “thing,” and my strategies have evolved over time. What I do today is nothing like what I did at the beginning. I took baby steps to get where I am now. Also, given my history and very high genetic risk, I try pretty hard. I’m also a bit of a geek, enjoy the science and trialing new strategies that lead to steady tweaks of my protocol. Secondly, it’s important to understand that every protocol is unique, based upon your specific risks and contributors that have led to your current state. It’s most important to identify whatever may be driving any potential pathology and specifically prioritize that. That said, many of the strategies I use are straight from the Bredesen Seven and are foundational to preventing and reversing all of Dr. Bredesen’s Alzheimer’s subtypes.
And, for the curious, just popping in to take a look; you probably think this doesn’t pertain to you. You probably think your cognition is just fine. You likely aren’t aware of any potential contributors that could one day lead to dementia. I was the same, eight years ago, when I was turning 50. It wasn’t until I learned of my high genetic risk (two copies of the ApoE4 allele) that I took a hard look at my cognition and learned that I was scoring in the mid-30th percentile for my age group. Because cognitive decline can be very insidious, and those affected are often not aware, I invite you to do a cognitive health check-up that takes about 20-30 minutes. It’s free, private, and provides feedback based on clinical research. If you’re unhappy with your results, Apollo Health has several programs that can help. Keep in mind that the pathology behind Alzheimer’s takes decades to develop before one finally receives a diagnosis. The sooner you take action, the better the program works. Take it from me — now healthier than I’ve ever been in my adult life, 20 lbs lighter, and scoring in the high 90th percentile for my age group — your older self will thank you.
Before I dive into my protocol, I have to acknowledge my amazing husband, Bruce, who’s been on this healing journey with me. He’s not only walked beside me in terms of offering support but he’s also adopted the vast majority of my diet and lifestyle changes … and benefitted greatly. He’s lost 30 lbs, traded his spare tire for muscle, and no longer takes any prescription medicine. As an international airline pilot, he’s stunned by the poor attention and stamina displayed by his younger co-pilots who rely on carbohydrates for fuel. In turn, they can’t believe he’s so full of energy while fasting for extended periods. Many have begun to ask for health tips and have ultimately chosen to follow his example. In fact, at a recent semi-annual FAA-required physical, his physician asked him to reveal his secret to aging backward. For spouses who are on the fence about adopting the protocol, I promise it won’t hurt you, and am certain that much of my success lies in the fact that we’ve made this our lifestyle as opposed to my treatment.
My Protocol
- I wake up around 5:00 to 6:00 am, without an alarm, after seven to eight hours of sleep. I’ve gotten into a very ancestral circadian rhythm where I go to bed with the sunset and wake up with the sunrise. I love my mornings and wake up full of energy and purpose to take on the new day.
- Upon awakening, I take 15 minutes to meditate. I use a version of transcendental meditation that I learned through Ziva. This practice provides a sense of centered awareness that helps me make mindful choices throughout the day.
- I skip breakfast and enjoy a cup or two of mold-free, organic coffee, no cream, with a very small amount of SweetLeaf stevia. I’m very careful to stop all beverages containing caffeine early in the day, typically before 9 AM. If I cheat with an early afternoon cup of coffee as a pick-me-up, my sleep is definitely affected.
- To protect the enamel on my teeth from the acidity in my coffee, I rinse (swish) my teeth with water before gently brushing them with non-fluoride toothpaste.
- I also use aluminum-free sunscreen and deodorant. I always consult the Environmental Working Group’s Skin Deep Database to find the safest toiletries and cosmetics.
- I then head outside almost every single day, regardless of the weather, and enjoy at least a 3.5-mile walk or run. This is my favorite part of the day. I find spending time in nature to be very healing. I love seeing the seasons and wildlife and feeling the weather on my skin. I live near the shores of Lake Michigan and experience tremendous weather extremes, from wind gales that make it difficult to walk to temperatures well below zero. This is a way for me to practice hormesis — the theory that regular exposure to adversity builds strength.
- I like to combine strategies and sometimes listen to educational podcasts or take an online class as I’m exercising. Other times, I listen to my favorite music to either energize me or meditative music if I need to problem solve. I also love letting my mind wander while listening to nature.
- Upon returning home, I’ll shower with non-toxic Castile soap if I’m sweaty. Several times a week, I hop into my low-EMF portable sauna before showering to aid in additional detoxification and create shock proteins that repair damaged proteins in my body and help to heal oxidative damage prior to showering.
- I then prepare a big glass of room temperature matcha tea (high in neuroprotective epigallocatechin gallate) with silica water (which helps to chelate aluminum) and put all of my morning supplements, which tend to be energizing, in a little ramekin and head up to my office to begin my day of work. It’s much less daunting to swallow supplements when I do it slowly, sometimes over an hour, while I’m working. (Apollo Health subscribers can see a full list of my supplements plus additional details here.)
- As I work, I make a point of walking around for ten minutes of every hour. Because I work from home, this is a great opportunity to do household chores, which I’ve learned to reframe as “exercise opportunities.”
- I alternate between a 16 to 20-hour fast, typically eating one meal a day, sometimes two. See Cognitive Restoration Through Fasting to learn more about the benefits of fasting. I realize that this feels extreme to many people. Keep in mind that it took me a long time to get to this point. When I first began the protocol, I was insulin-resistant and often awoke with hypoglycemia in the middle of the night and had to eat a snack. I took baby steps to heal my metabolism, which enabled my body to be able to get into ketosis so I can now easily fast for long periods. See Why Ketosis is Important for Brain Health to learn more and for instructions on how to create metabolic health. Your ultimate goal is to create metabolic flexibility — the ability to use either glucose or fat as fuel — to optimize the fuel supply for your brain while staying weight-stable and strong.
- My ketones are often at the highest point of the day (typically between 1 to 2 mM) right before I break my fast. I sometimes check my ketones, but rarely check my glucose at this point in my recovery. My Hba1c has been steady between 4.7 to 4.8 for years. While regular glucose and ketone checks and journaling my food intake with Cronometer were very helpful in the beginning, I no longer need that level of detailed tracking. Apollo Health subscribers can find instructions in Monitoring Metabolic Health: Tracking Glucose and Ketones.
- Prior to breaking my fast, I drink a glass of water with lemon and/or ginger to detoxify, and I take two glucosamine chondroitin capsules to help with lectin sensitivity. (Lectins, such as gluten, are sticky plant proteins that can cause inflammation for those who are sensitive.) Even though I generally eat a grain-free, low-lectin diet, I concurrently use glucosamine chondroitin to help block the effects of those still remaining in my diet.
- If I eat two meals, which I do when I notice a downward trend in my weight, my first meal would be enjoyed after noon and would typically include two pastured eggs with a plateful of non-starchy organic vegetables comprised of leafy greens, cruciferous, and colorful vegetables (some raw, some cooked) including prebiotic fiber like jicama, mushrooms, or scallions along with a small amount of resistant starch such as a few cooked and cooled sweet potato wedges along with a few tablespoons of fermented vegetables. I finish my vegetables with liberal amounts (several Tbsp) of high polyphenol extra-virgin olive oil, with fresh herbs and spices, along with Himalayan sea salt and dried sea vegetables for iodine.
- After each meal, I carefully floss and gently brush with non-fluoride toothpaste. Because there is a strong link between oral and brain health, I also have my teeth professionally cleaned three times a year as opposed to twice a year, even though I don’t have any ongoing periodontal or other issues.
- A few times a week, I drink a cup of grass-fed bone broth for its gut-healing benefits, along with a meal.
- Between 5 to 6 days a week, I engage in a 30-minute KAATSU strength training program. This is a Japanese practice that mildly restricts blood flow to the arms and legs that tricks my muscles into thinking they’re working much harder than they are actually working. The benefit is two-fold. One, I’m increasing my muscle strength without actually breaking down muscle fiber. This is a huge benefit for everyone, but especially for those who are middle-aged and older. Secondly, by creating this mild hypoxic state in my muscles, I’m upregulating many healing growth hormones, like BDNF and plasmalogens, which also have neuroprotective benefits. You can read about some benefits here. There are multiple ways to access this workout, ranging from the use of manual bands for $29.99 to automatic battery-operated pneumatic bands for $900+. Be aware that while KAATSU has an excellent safety record if practiced incorrectly, you can still hurt yourself. I’ll put together a more in-depth article next month on how to safely use KAATSU at home in various ways at different price points.
- After exercise or sauna and throughout the day, I’m careful to stay hydrated. I sip room-temperature filtered water or S. Pellegrino as a refreshing way to replenish minerals. As mentioned earlier, I also use sea salt to avoid the keto flu and maintain fluid balance. Staying well-hydrated also promotes optimal detoxification.
- I usually take a mid-afternoon break from work and challenge myself to a 20-minute brain-training session using BrainHQ or another brain-training site. I’m currently experimenting with Elevate, and I like that the exercises translate into tangible improvements in my real-life performance.
- Afterward, I like to meditate for another 15-minute session. I’m not always faithful to this second session, but I feel so much better when I can squeeze it in. The regular practice of meditation has tremendous mood, energy, and sleep benefits.
- I eat my second meal between 4:00 to 5:00 pm or a bit earlier or from 2:00 to 3:00 pm if I’m just eating one meal. If my husband is home, we make this main meal a time of celebration. We’ve typically been apart, focused on our own schedules, and this is our chance to reconnect and nurture with food. We often plan our menu over coffee in the morning and cook together. A typical meal might include wild-caught fish, such as Alaskan sockeye salmon, with a large, colorful salad consisting of a variety of colorful, non-starchy, high-fiber organic vegetables (some cooked, some raw) dressed liberally with high polyphenol EVOO, lots of fresh herbs, and spices, Himalayan sea salt, and dried sea vegetables for iodine. If this is our only meal of the day, we typically alternate between pastured eggs or low-mercury, wild-caught seafood as the protein. We always include a little bit of resistant starch, prebiotic fiber, and fermented veggies on our plates.
- I refrain from snacking between meals, but if I’m only eating one main meal (sticking to a 4-hour window of eating), I freely nibble as I cook and even snack an hour or so afterward. This helps me maintain my weight without gorging myself at one sitting.
- I occasionally enjoy dessert during my eating window. One of my favorites is raw organic walnuts, julienned almonds, coconut flakes, and wild berries drizzled with sugar-free nut or goat milk. Another treat would be a carefully chosen (low cadmium and lead) dark chocolate square, 86 percent or higher cacao.
- I stop eating by 6:00 pm (often much earlier) and put on my blue-blocking glasses if I’m still using screens or artificial light. I prefer to dim the lights during this wind-down period and try to refrain from stimulating work or conversations.
- I like to take my evening supplements an hour or so before bed with just enough water to safely swallow them so I can avoid bathroom runs in the middle of the night. Apollo Health subscribers can see my full list here.
- Before bed, using dim blue-blocking light, I gently wash my face with a non-toxic cleanser and use the Ayurvedic practice of oil pulling with coconut oil, which has anti-microbial properties. I just melt 1-2 tsp of coconut oil in my mouth and pull it through and around my teeth for 15 minutes. I find this very relaxing, and (I don’t understand why) it also helps me to sleep much more deeply.
- I like to get into bed (not necessarily to sleep) by 8:00 pm. I often use this time to read pleasurable fiction using the Kindle app on my iPad with the light set to the lowest setting and Night Shift enabled to block blue light. I’ve also selected the device to automatically turn itself off if I stop moving for 5 minutes.
- During this wind-down period, my husband and I often run some additional passive KAATSU sets with our automated pneumatic systems. The bands inflate and deflate themselves while we’re relaxing and reading in bed. I sometimes unconsciously engage in gentle isometric exercises during this time. I notice that running through several KAATSU cycles before bed helps me to fall asleep quickly and sleep more deeply.
- I completely darken the bedroom before sleep. Any small amount of light can interfere with melatonin production. Additionally, I sleep on an Ooler cooling mattress pad set to 65°F with a weighted blanket.
Keep in mind that I rarely perfectly practice my own protocol. I just do the best I can. As I’m faced with dozens of decisions throughout each day, I’m fully aware that some move me towards health while others move me away from health. As I encounter these forks in the road, I recall a stark yet poignant quote from Shawshank Redemption that beautifully summarizes the ultimate consequence of my choices and helps to keep me on track, “Get busy living or get busy dying.” I do my best to consciously choose life every single day. The benefits have been enormous, rendering the protocol quite sustainable for me. Indeed, when I decided to put my brain health first, I was stunned to find that many of my previous health issues completely disappeared. I now feel healthier and stronger — with calm, steady energy throughout the day — than at any other point in my adult life.
If you’re interested in learning more about Dr. Bredesen’s protocol, consider reading his most recent book, The End of Alzheimer’s Program. I was honored to help him and his wife, Dr. Aida Lasheen Bredesen, an integrative physician, write the handbook portion that provides step-by-step instructions on how to practice the protocol. If you’re not ready to fully commit to a lifestyle makeover, consider adopting a few of my strategies and note how they make you feel. Every journey begins with a single step.
Be well-
Julie